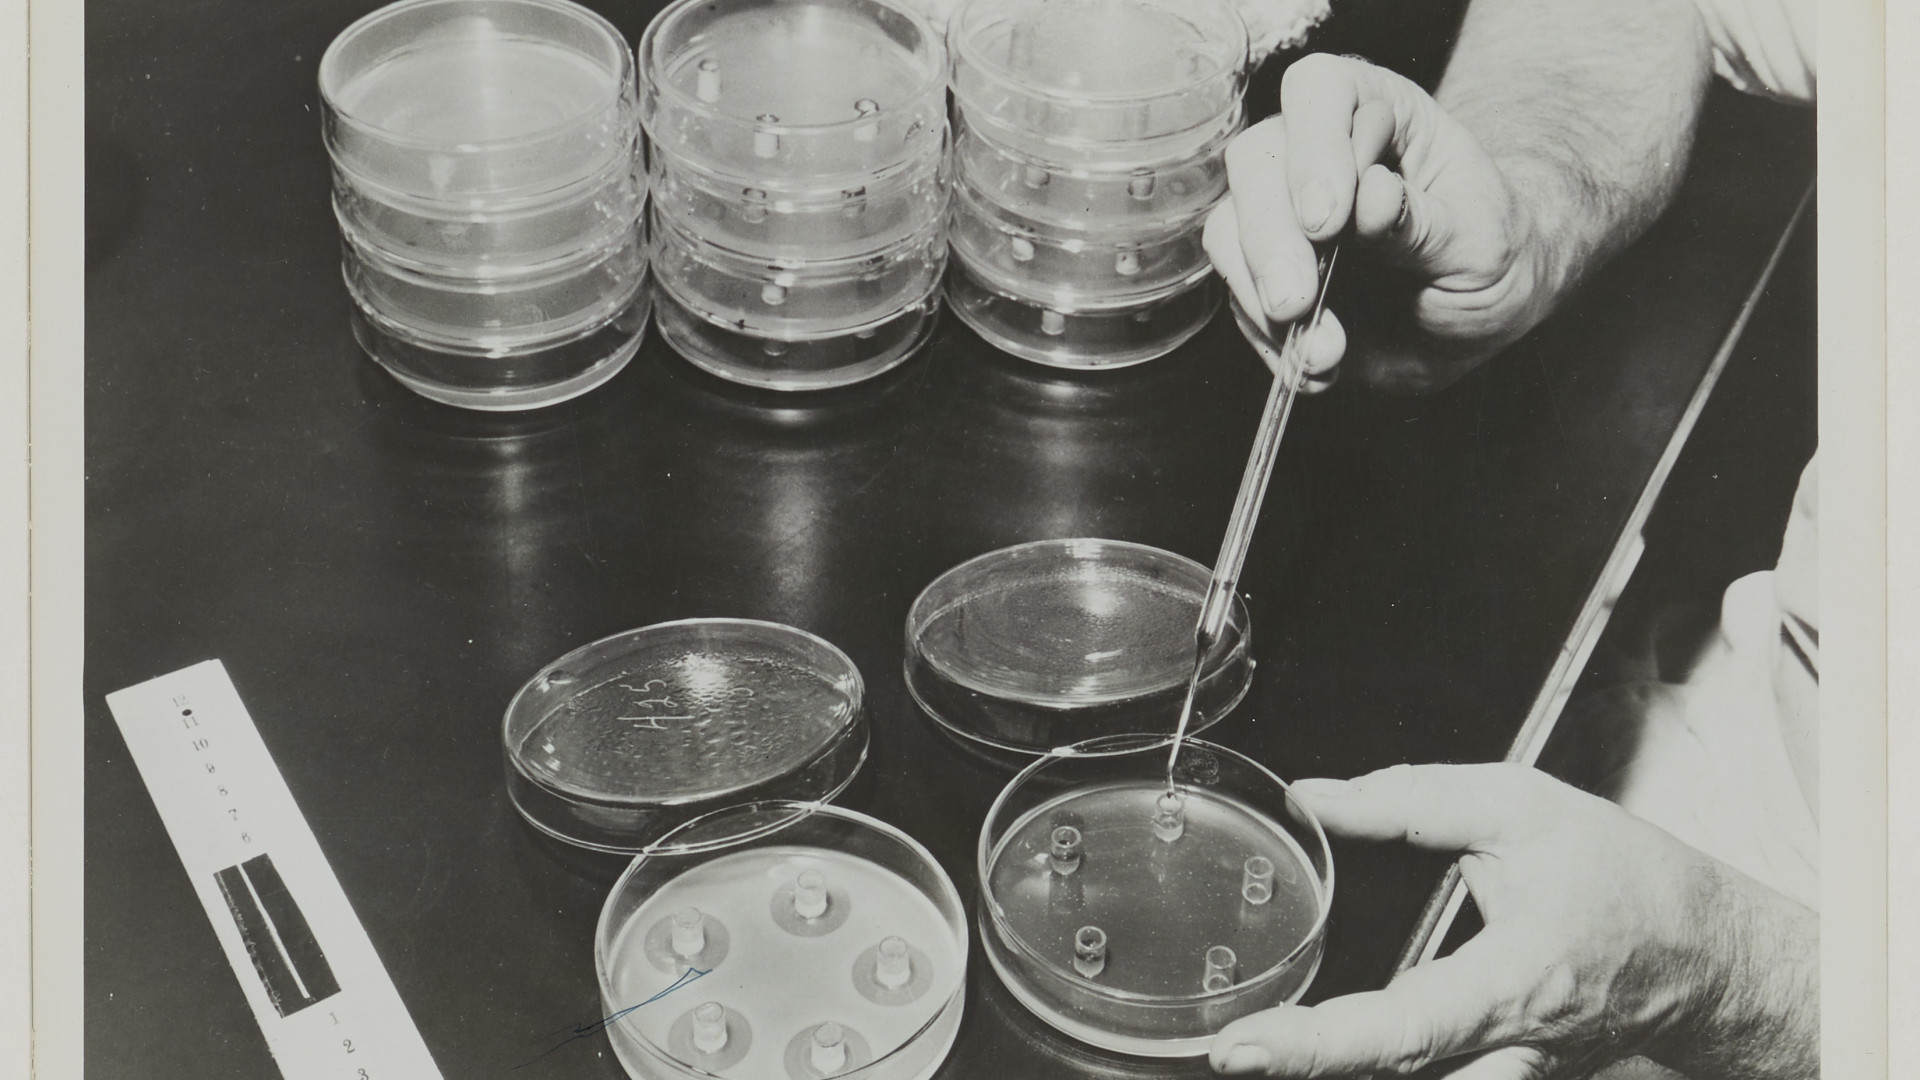

20 Major Events From The Past That Changed Life As We Know It
Earth Shattering History
Significant events in history have shaped the way the world has become. From scientific discoveries to devastating wars, humanity has gone through some massive changes. We’ve noted twenty of the most crucial events that have shattered and reshaped life on Earth.
1. The Neolithic Revolution
The Neolithic Revolution, a.k.a. The Agriculture Revolution, dates all the way back to 10,000 BC and was a significant turning point in the way of life for humanity. Humans no longer needed to travel far and wide to hunt and gather their food, they discovered how to grow crops and domesticate animals in one location. Villages were established due to agriculture which eventually grew into cities.
 Holger Uwe Schmitt on Wikimedia
Holger Uwe Schmitt on Wikimedia
2. The Invention Of Writing
The invention of writing might not seem as major as a war or a scientific discovery but it might be the most revolutionary event that changed the world. Writing changed the way people communicated and societies operated. Laws and morals of civilizations were established and knowledge could be preserved and passed on from generations. Books are more powerful than ever.
3. The Roman Empire Expansion
From 27 BC to 476 AD, the Roman Empire expanded until it occupied all of Europe, North Africa, and the Middle East. Much of our modern political system is rooted in the legal systems of the Romans. With Latin as their mother tongue, language was also a major contribution of this ancient empire. Many languages, including French, Italian, and even some English, stem from Latin.
 Federico Di Dio photography on Unsplash
Federico Di Dio photography on Unsplash
4. Christopher Columbus & Colonization
Colonization was born after Christopher Columbus spread the word of his discovery of America. Europe’s nations began to settle in new territories, bringing their resources and technologies with them and causing radical changes. Civilizations were merging with some positive but mainly negative interactions, but Europe ultimately seized most of the land.
 L. Prang & Co., Boston on Wikimedia
L. Prang & Co., Boston on Wikimedia
5. The Industrial Revolution
The Industrial Revolution had a dramatic impact on the world socially and economically. The shift from an agricultural society to an industrial economy brought significant change to the manufacturing of goods that could now be produced on a massive scale. The invention of the steam engine was the first technology to spark the industry, followed by machinery that allowed production to be done quicker and without manual labor.
6. World War I
Several wars altered the state of the world throughout history but WWI and WWII defined the course of humanity the most. The First World War took place between 1914 and 1918 which caused great change to the European and Middle Eastern borders. New countries were established such as Austria, Hungary, and Lithuania, and Yugoslavia was created by merging Serbia, Montenegro, and the Austro-Hungarian Empire.
 Library of Congress on Unsplash
Library of Congress on Unsplash
7. World War II
The Second World War happened between 1939 and 1945 and defined what we know as the New World. Major consequences after the wars completely changed the world. A few significant examples include the founding of the United Nations, an organization to promote peace and bring nations closer together. Decolonization began to happen around the globe, especially in Africa, and technology advanced in computing, transportation, medicine, and more.
8. The Discovery Of Penicillin
Thanks to Alexander Fleming, the world of medicine changed forever. His discovery of penicillin created life-saving drugs and the era of antibiotics began. Penicillin is recognized as one of the greatest advances in medicine in history and it helped sick and wounded soldiers in the war, as experts raced against death to produce it.
Archives nationales (France) on Wikimedia
Archives nationales (France) on Wikimedia
9. The Great Depression
After the US stock market crashed, from 1929-1939 the Great Depression was a decade of heavy global economic downturn. Unemployment rates skyrocketed as businesses went bankrupt and there was a crisies of liquidity. Life was severely difficult for many people across the world and the time was considered early growing pains of globalization.
10. The Invention Of The Atomic Bomb
World War II ended after US atomic bombs struck Hiroshima and Nagasaki, instantly killing over 115,000 people followed by a further 100,000 people dying from radiation poisoning. The development of the bomb was reported to have started in 1942 and scientists were unaware of its magnitude. To this day, the threat of its mass destruction still lingers.
 United States Department of Energy on Wikimedia
United States Department of Energy on Wikimedia
11. The Civil Rights Movement
The 60s were a pivotal time for African Americans living in oppressive segregation in the USA. Significant leaders of the movement were the likes of Dr. Martin Luther King Jr., Rosa Parks, and Malcom X, who’s brave activism caught nationwide and global attention. Although racism is still among us, the Civil Rights Movement sparked drastic changes in equality for Black Americans.
12. Women In Justice
Sandra Day O’Connor was the first woman to ever be appointed as Supreme Court Justice in 1981. She made history, becoming a trailblazer for women in politics, carving the path for future female leaders.
13. JFK Assassination
When US President John F. Kennedy was assassinated in 1963, American and international politics changed forever. It was one of the most covered historical events of all time, being published in countless magazines and newspapers worldwide. To this day, JFK and his wife Jaqueline have been strong influential icons for politics and lifestyle.
14. The Moon Landing
In 1969, humanity saw a man on the moon for the first time ever. The moon landing is the most famous event in the history of science and technology. New revolutionary technology sparked from the world-shaking space expedite such as microwaves, smaller computers, and GPS systems, to name a few.
 Neil A. Armstrong on Wikimedia
Neil A. Armstrong on Wikimedia
15. The Fall Of The Berlin Wall
The Berlin Wall was a symbol of the “Iron Curtain”, splitting Communist authoritarian states and Eastern liberal democracies of Europe. The wall prevented East Germans to escape to the West. In 1989, the Berlin Wall began to crumble after German leaders loosened its borders, giving in to the massive protest that had stuck days earlier. The border opened up completely even though it wasn’t intentional.
16. The Russian Revolution
The Russian Empire was experiencing severe political, social, and economic issues in the early 1900s. In 1917, the revolution struck the civil war in Russia, which led to the world’s first communist state. Russia has been an incredibly powerful nation ever since, affecting international politics greatly.
 Unknown authorUnknown author on Wikimedia
Unknown authorUnknown author on Wikimedia
17. Chinese Communists Rise
In July 1921, the Chinese Communist Party was founded with the rise of Mao Zedong and Red China. It only took three weeks to convene its first National Congress. It not only caused havoc in their nation, it's been brought major challenges to the world. Communism in China reigned for the next 28 years before the nation became the People's Republic Of China.
 孟庆彪(新华社摄影部中央新闻组记者)、Hou Bo(新华社驻中南海记者) on Wikimedia
孟庆彪(新华社摄影部中央新闻组记者)、Hou Bo(新华社驻中南海记者) on Wikimedia
18. The Terrorist Attacks Of 9/11
Four hijacked passenger planes on September 9, 2011, devasted the world and caused intense changes. After being struck by the planes, the two towers of the World Trade Center collapsed along with Pentagon building in Washington DC. Since this terrorist attack, airport security and anti-terrorist legeslations have increased protocols drastically and the world has never been the same since.
19. The Age Of Google
Google was launched in 1998 and has changed life more than we know. It is the most used and recognizable search engine in the world and the internet has been changed every since. It has sparked many other internet advances, connecting the world together on screen.
20. Covid-19 Pandemic
The outbreak of the Covid-19 virus in early 2020 shattered our modern world dramatically. For the first time, countries around the world shut their borders completely as the fatal virus spread rapidly. The most recognizable changes coming out of this pandemic are the increase in remote workers, the housing crisis, and polarizing views of vaccinations.
KEEP ON READING

10 Greatest Quarterbacks Of All Time & 10 That Overrated
Do You Disagree?. Few topics in sports generate as much…
By Farva Ivkovic Dec 2, 2025
The story of Ching Shih, the Woman Who Became the…
Unknown author on WikimediaFew figures in history are as feared…
By Emilie Richardson-Dupuis Dec 29, 2025
20 Shakespearean Words, Translated For A Modern Audience
What’s In A Word?. Shakespeare was a wordsmith of the…
By Breanna Schnurr Dec 17, 2025
20 Inspiring Stories From Native American History
Incredible Stories Of Resilience And Endurance. Many of us didn't…
By Ashley Bast Dec 17, 2025
You Think You Have Problems? These Royal Families Were Cursed
Boasson and Eggler St. Petersburg Nevsky 24. on WikimediaHeavy is…
By Ashley Bast Dec 5, 2025
MH370: The Plane That Can't Be Found
Anna Zvereva from Tallinn, Estonia on WikimediaEleven years after Malaysia…
By Christy Chan Dec 10, 2025












